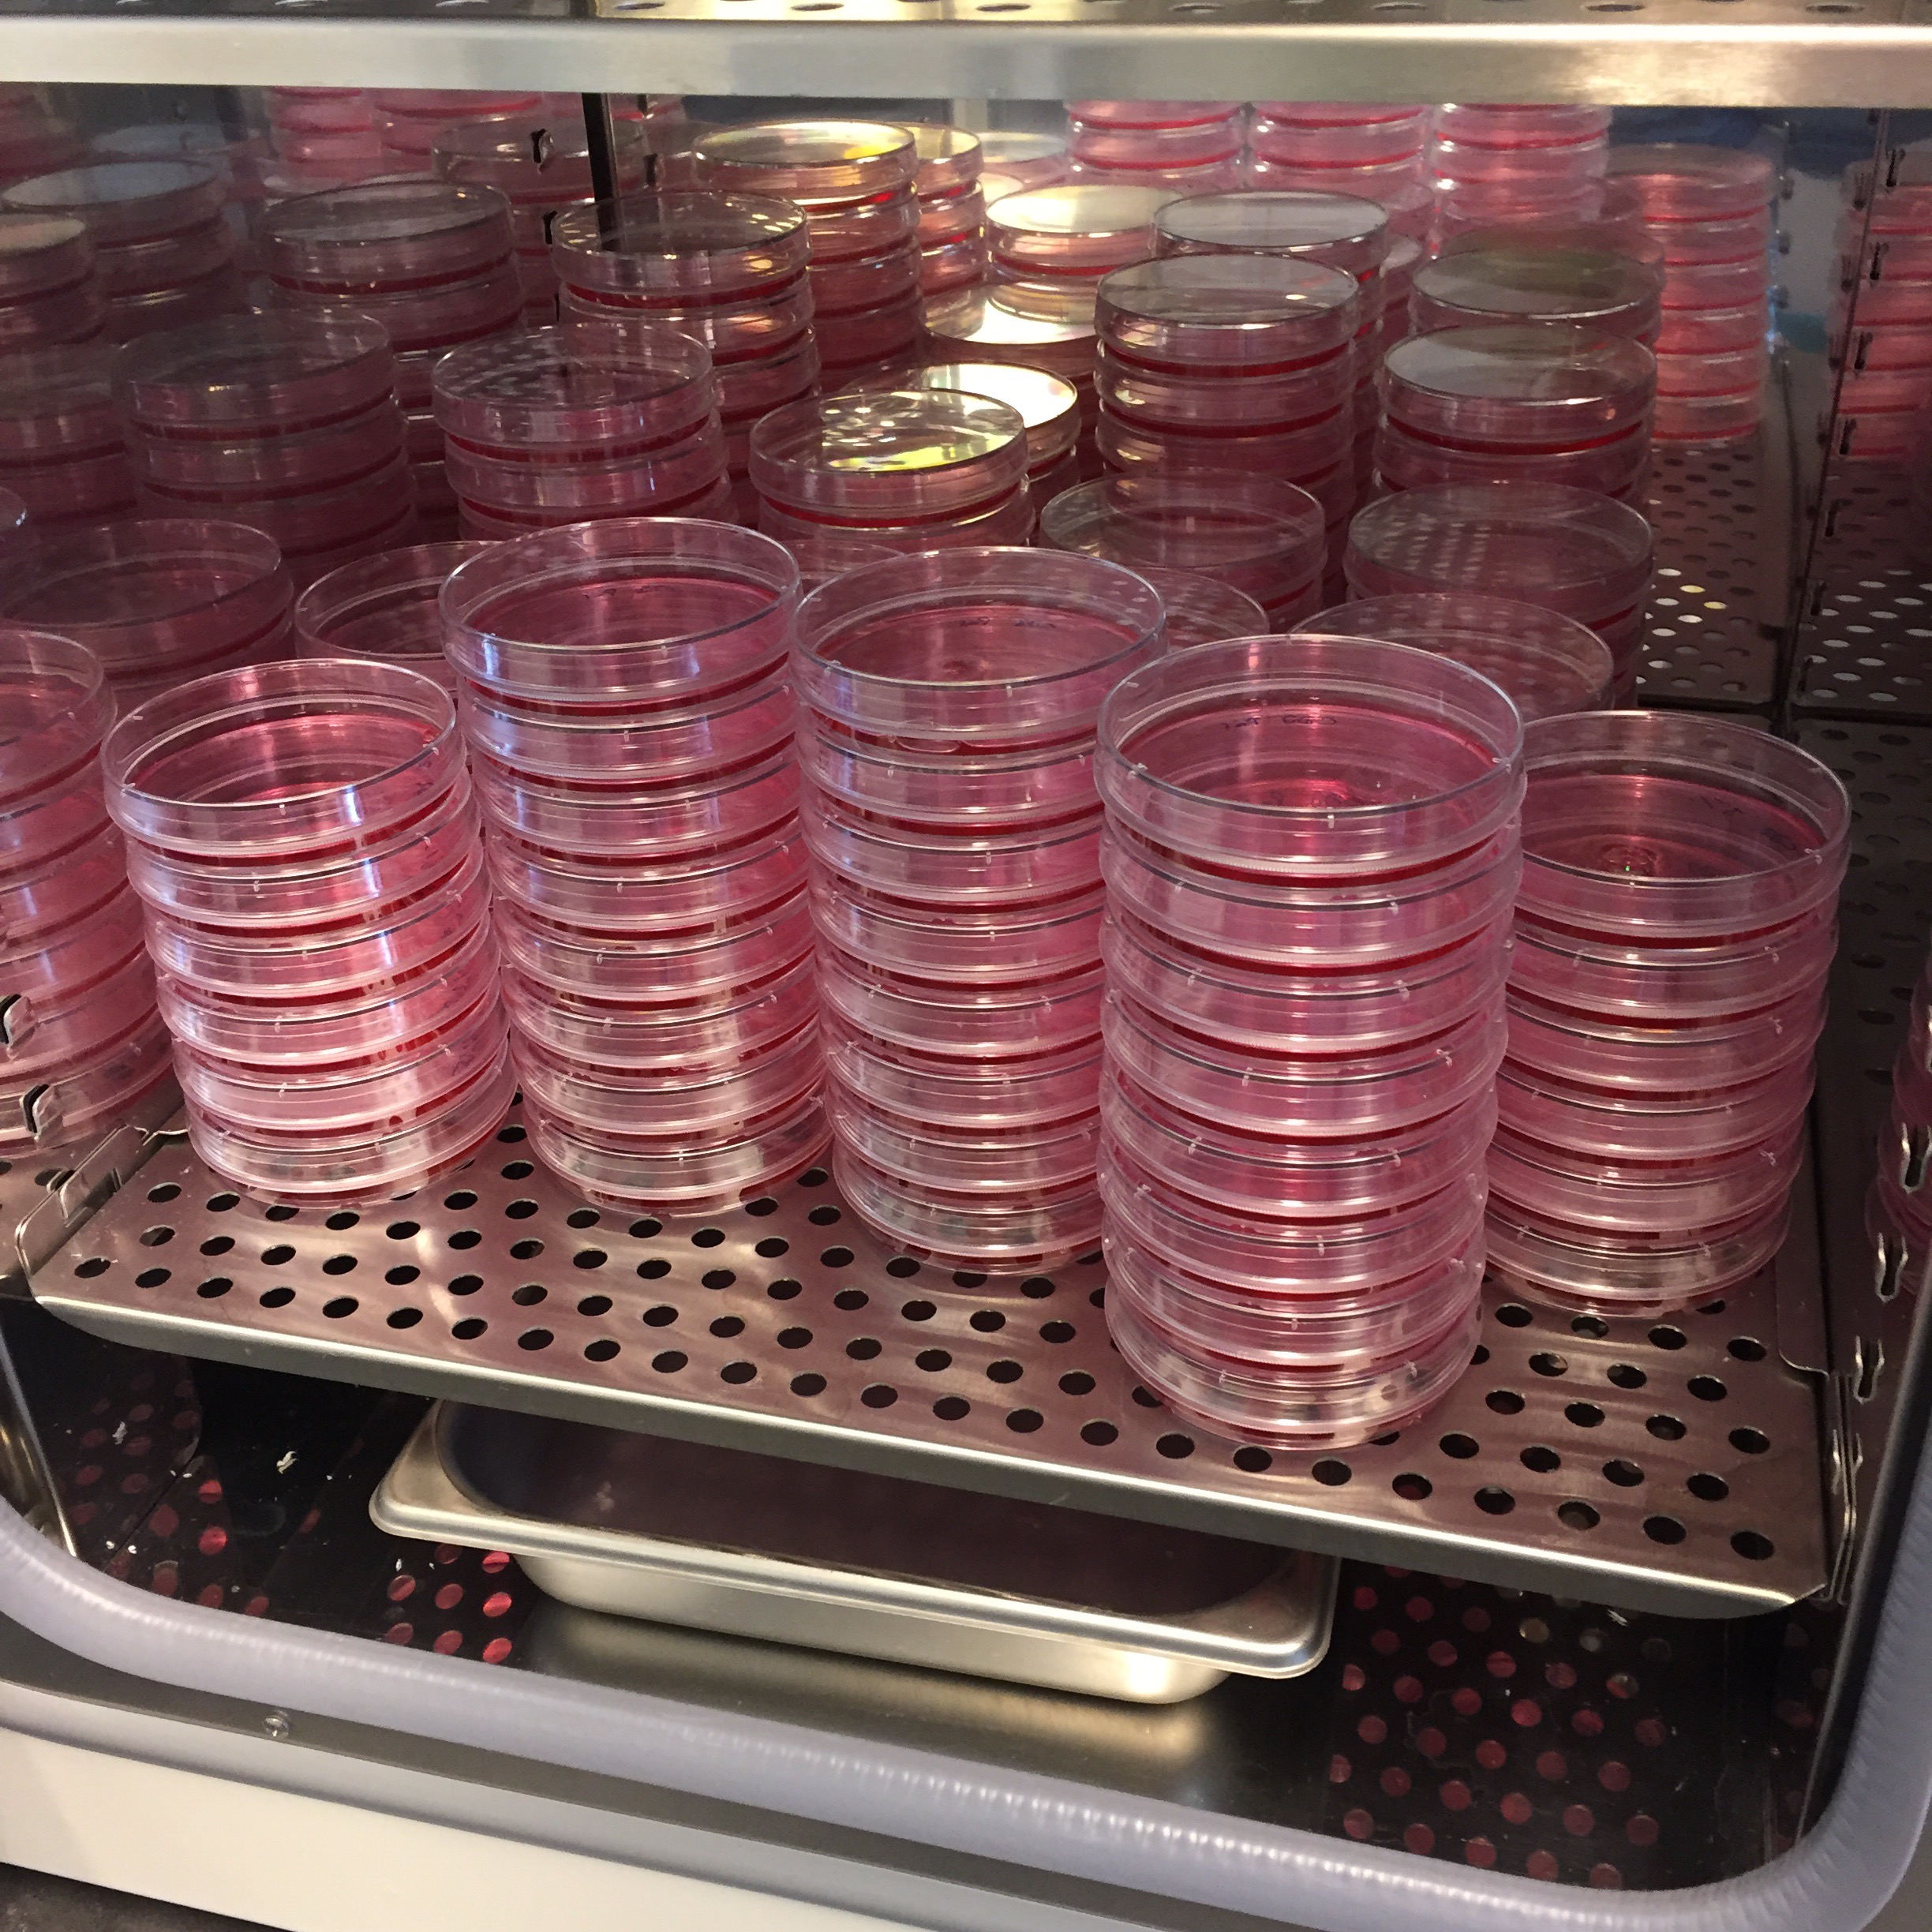

Prööööt! Der Rabensalat hat tatsächlich Geburtstag und das eigentlich sogar schon gestern, aber der erste Post war unnummeriert und deshalb passt das schon! Ich kann zählen, Juhuuu!
Ein Jahr Bloggerei, jeden Tag. Hammer. Obwohl ich ehrlich gesagt ja schon ein Typ bin, der Sachen einfach durchzieht, wenn sie vorgenommen sind, egal als wie scheiße sie sich zwischendurch herausstellen: allerallermeistens hat es Spaß gemacht. Allerallerallermeistens. Sogar viel. Hier hab ich ein Medium, dem ich mich mitteilen kann, das mich zuallererst mal nicht auslacht für den wirren Kram, der mitunter meinem Hirn entspringt. Dann hab ich jetzt auch ein online-Gedächtnis, das ist manchmal ganz praktisch und ich bin sicher, in ein paar Jahren wird es noch praktischer sein, die eigenen Erinnerungen quasi googeln zu können (wobei das auch ziemlich gruselig ist, wenn man so genauer drüber nachdenkt…). Und was mich ehrlich am meisten überrascht: hier sind total viele nette Leute. Also hier, auf dem Blog, Menschen die nur lesen, Menschen, die auch mal kommentieren, Menschen, bei denen man auch selber liest (das wird total weird sich irgendwann mal im richtigen Leben gegenüber zu stehen!) und irgendwie kennt man sich ein bisschen, obwohl man sich noch nie getroffen hat. Ich mag das sehr.
Auch bei Twitter habe ich mir inzwischen eine bunte Timeline zusammengebastelt und unheimlich nette Leute in 140-Zeichen-Häppchen kennengelernt. Manchmal wenn dann große Twitterer- oder Bloggertreffen sind, ärgere ich mich, so weit weg zu sein. Und dann fällt mir wieder ein, dass ich ja Westfale bin und bei zu vielen fremden Leuten um mich rum schweigsam in mein Bier starre. Aber schon allein mal persönlich Leuten danken: für Kindersitze in Wien, für Rat bei Hautproblemen, für Beruhigung bei „Hilfe, mein Baby hat da was am Zahnfleisch!“ – das würde ich gerne mal persönlich machen.
Insgesamt hier also große Blogbegeisterung nach dem ersten Jahr. Doch. Das mache ich noch eine Weile weiter.
Darauf ein Gläschen Weißweinschorle bei sommerlichen 6 Grad und Regen hier und dann bestelle ich mir das erste Jahr ausgedruckt als Buch. Weil ich das eine total tolle Idee finde, die ich Frau Brüllen abgeschaut hab (Ehre wem Ehre gebührt und 12 Jahre! Respekt.)
In diesem Sinne Prost und bis morgen –
Ihre Frau Rabe